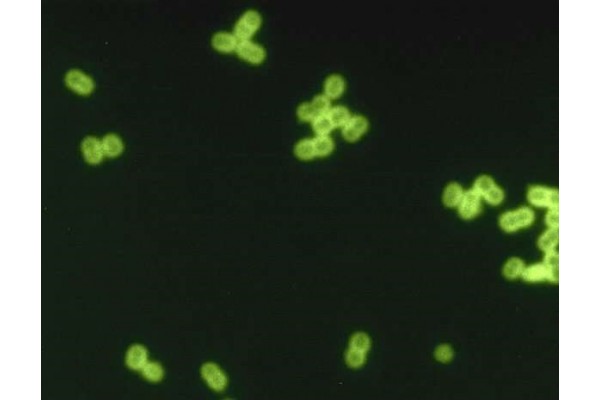

一个英国研究团队指出,增强对细菌免疫力的疫苗可以让接种者免于耐药性细菌的感染,并强调,疫苗还可以减缓耐药菌株在人群中的传播。
为了更好地了解疫苗对细菌耐药性的影响,科研人员建立了四个维度的数学模型。他们发现,尽管接种疫苗可以预防耐药性细菌,讽刺的是,疫苗同样也能促进耐药性在人群中的传播。科研人员表示,目前需要一个正确的接种策略来预防耐药毒株。
该英国团队在27个欧洲国家模拟了疫苗接种和耐药性情况,得出了一系列关于疫苗接种及其与超级细菌的控制和传播关系的新结论。
这种了解耐药性驱动因素的方式来自伦敦卫生与热带医学学院(london school of hygiene and tropical medicine)尼古拉斯·戴维斯(nicholas davies)博士的研究。与研究的共同作者凯瑟琳·阿特金斯(katherine atkins)博士和一个研究团队一起,他们共同开发了一个建模系统,该系统将细菌物种的多样性和它们之间的竞争纳入耐药菌株进化原因的研究中。
戴维斯、阿特金斯与合作者们共同在《科学转化医学》(science translational medicine)期刊上发表了一篇文章,该文章对27个国家中的青霉素的使用与青霉素“不易感性”对肺炎链球菌的耐药性进行了研究。他们的数学模型显示,肺炎链球菌(也称肺炎球菌)的抗生素敏感毒株与抗生素耐药菌株常常共同存在于人群中。他们说,必须谨慎选择疫苗接种策略,以免打破这种平衡,给超级细菌传播创造有利条件。
戴维斯及其同事断言:“竞争和多样性是抗生素耐药性进化的关键,同时也将决定疫苗对耐药性感染究竟是起到预防还是促进的作用。”
肺炎链球菌是一种常见且普遍存在的微生物,它能入侵人体的各个部位,导致严重的甚至危及生命的感染。如果入侵肺部,会导致肺炎球菌肺炎;如果入侵耳朵,则表现为造成感染性耳痛的中耳炎;如果入侵鼻道,则会引起鼻窦炎;如果入侵血液,则可能发生一种称为“菌血症”的严重感染。肺炎球菌还可能引起脑和脊髓感染,诊断为细菌性脑膜炎。
同戴维斯和他的研究小组一道,世界各国的研究团队已经解决了肺炎球菌疫苗对耐药肺炎球菌菌株的影响。想要理解众多的研究,关键要抓住一点:在人群中有限度地接种肺炎球菌疫苗会打破平衡状态,造成抗生素滥用以及儿童和成人肺炎球菌感染增加。这反而为本来就难以消灭的耐药菌株提供了进一步进化和传播的机会。简而言之,越来越多的人使用抗生素治疗,而这是本该避免的。过度使用抗生素是耐药性增强的一大驱动因素。
“针对细菌病原体的疫苗可以让接种者预防潜在抗生素耐药性病原体的感染。然而,通过改变抗生素敏感菌株和抗生素耐药菌株之间的平衡选择,疫苗或能抑制(或促进)抗生素耐药性在未接种疫苗的个体中的传播,”戴维斯团队写道。
阿特金斯说,这项研究为更好地了解疫苗和耐药性之间不断变化的关系奠定了基础。
“我们的研究并未关注目前已经获得许可的、具备安全性和有效性且在全球范围内减少威胁生命的疾病的肺炎球菌疫苗,”共同作者阿特金斯说。她指出:“相反,我们研究了新一代肺炎球菌疫苗的影响,研究的结论强调对真正有效的(普适)疫苗的需要,因为它能减轻药物敏感和耐药感染的负担。”
戴维斯及其同事的研究文章发表时,正值世界卫生组织倡导加强对抗微生物药物(包括抗生素)滥用、误用和过度使用的劝导。世卫组织的数据表明,尽管大力宣传停止为患者开具不必要的抗生素处方,并停止给肉类养殖的动物提供的饲料产品中使用抗生素,2000年至2015年间,全球抗生素的使用量仍然增加了65%。
世卫组织预测,除非立即采取措施扭转推高全球抗微生物药物耐药性发生率的趋势,否则,到2050年,全球因耐药性导致的死亡人数将超过癌症患者的死亡人数。就目前而言,药物滥用将促进更多无法治愈的超级细菌的产生。一些研究人员指出,在肺炎球菌感染方面,我们至少还有凯发k8天生赢家一触即发的解决方案,那就是研发一种针对更多肺炎球菌血清型疫苗。
现有的肺炎球菌疫苗仅针对已知的100多种肺炎球菌血清型中的一部分。pcv13(也称为 prevnar)是一种常见的肺炎球菌疫苗,它可以针对13种肺炎链球菌血清型:分别为血清型 1、3、4、5、6a、6b、7f、9v、14、19a、19f、18c和23f。ppsv23疫苗能针对更多的血清型:包括prevnar中的13种在内的23种血清型。然而,还有其他数十种肺炎球菌血清型没有疫苗。
戴维斯、阿特金斯及其同事认为:“细菌疫苗和抗生素耐药性的交叉需要进行更多研究”。例如,他们利用四个数学模型,发现了抗生素耐药性的潜在模式。这些模型还揭示了特定国家的因素,例如耐药细菌和药物敏感细菌之间的竞争差异。研究人员发现,肺炎球菌疫苗的类型很大程度上决定了疫苗对抗生素耐药性进化的影响。例如,研究人员预测,与能加速消灭细菌的普适性、非血清型特异性疫苗与仅能预防感染的疫苗相比,前者可能更利于抑制抗生素耐药性血清型的传播。
在英国团队研究耐药性模式的同时,其他研究小组已经在研究接种疫苗如何在防止耐药细菌出现,并从中节省资金。
北卡罗来纳州立大学和北卡罗来纳大学教堂山分校的研究人员发现,在美国,利用疫苗减缓抗菌素耐药性进化时,可以节省大量的经济成本。
专门研究埃塞俄比亚的肺炎球菌感染的安德鲁·斯金格博士和(andrew stringer)和小泽幸子(sachiko ozawa)利用自建数学模型发现,肺炎球菌疫苗有助于减缓阿莫西林耐药细菌传播速度,幅度约15%。研究结果显示,虽然疫苗接种对减缓对头孢曲松耐药细菌的传播速度较为一般,仅为0.59%,但至少其发展方向是正确的。
美国的研究者预计,若将肺炎球菌疫苗的接种保持在模型结果水平,每年将额外为埃塞俄比亚节省767万美元。此外,这笔节省的资金也不会再浪费在治疗由耐药性肺炎球菌感染所引起的疾病上。
北卡罗来纳州兽医和全球健康助理教授斯金格在一份声明中表示:“为了表明接种疫苗可以减少这些疾病造成的残疾或死亡,并对接种疫苗是否可以减缓抗菌素耐药性进行量化,我们希望能对疫苗接种带来的价值进行建模。”
在英国,戴维斯和他的同事开发了四个模型,发现了抗生素耐药性的潜在模式。例如,对于肺炎球菌感染和抗生素耐药性都很高的高负担区域模型中,需要有高效的疫苗来降低耐药性。作者总结说,上述发现“(强调了)利用疫苗应对抗生素耐药性的政策必须针对特定的病原体和环境量身定制。”
来源:https://medicalxpress.com/news/2021-09-vaccination-bacterial-infections-superbugs-populations.html
图片来源于网络
关于滴度医贸网
是专注于全球药品、医疗器械b2b在线采购及推广平台。作为行业先驱,我们致力于加速药品、医疗器械在全球范围内的流通,让跨境医贸业务变得更简单、更高效。通过领先的技术和在国际医贸行业的专业知识储备,平台为全球数十万医疗行业供应商和采购商构建交流渠道、拓展海外商机、提供全方位的凯发k8天生赢家一触即发的解决方案。